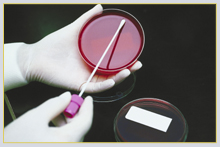

|
|
|
|
|
|
For over 35 years, Rachel Klar, MSc., has owned and operated the New Rambam Laboratories. The laboratories are equipped with the most innovative analytical systems, thus enabling results within hours for an extensive range of tests, without compromising quality or accuracy. Modern technology (of the reagents and the equipment) contributes to this high standard. |
|

|
The laboratory specializes in the following tests: Biochemistry, Hormones, Viruses (including AIDS), various cultures, Parasites in feces, blood and urine, Cancer markers, etc.
New Rambam Laboratories are the sole laboratories in Israel performing Acitest, Fibrotest and Fibromax tests which evaluate the state of the liver for carriers of Hepatitis B and C and fatty liver. The blood tests are simple and non-invasive.
|
New Rambam Laboratories is a member of external quality assurance programs, together with other well-known laboratories in Israel and the world, and is highly regarded in respect to other laboratories. The laboratory holds the ISO 9000 international stamp of approval.
A skilled, professional and courteous staff provides service of the highest standard in Hebrew, English, Russian and French.
|

|
New Rambam Laboratories do their utmost to serve the community of doctors and patients faithfully and efficiently and are happy to be of service at anytime, to answer any question or request. |
|
|
|
|
|
|
|